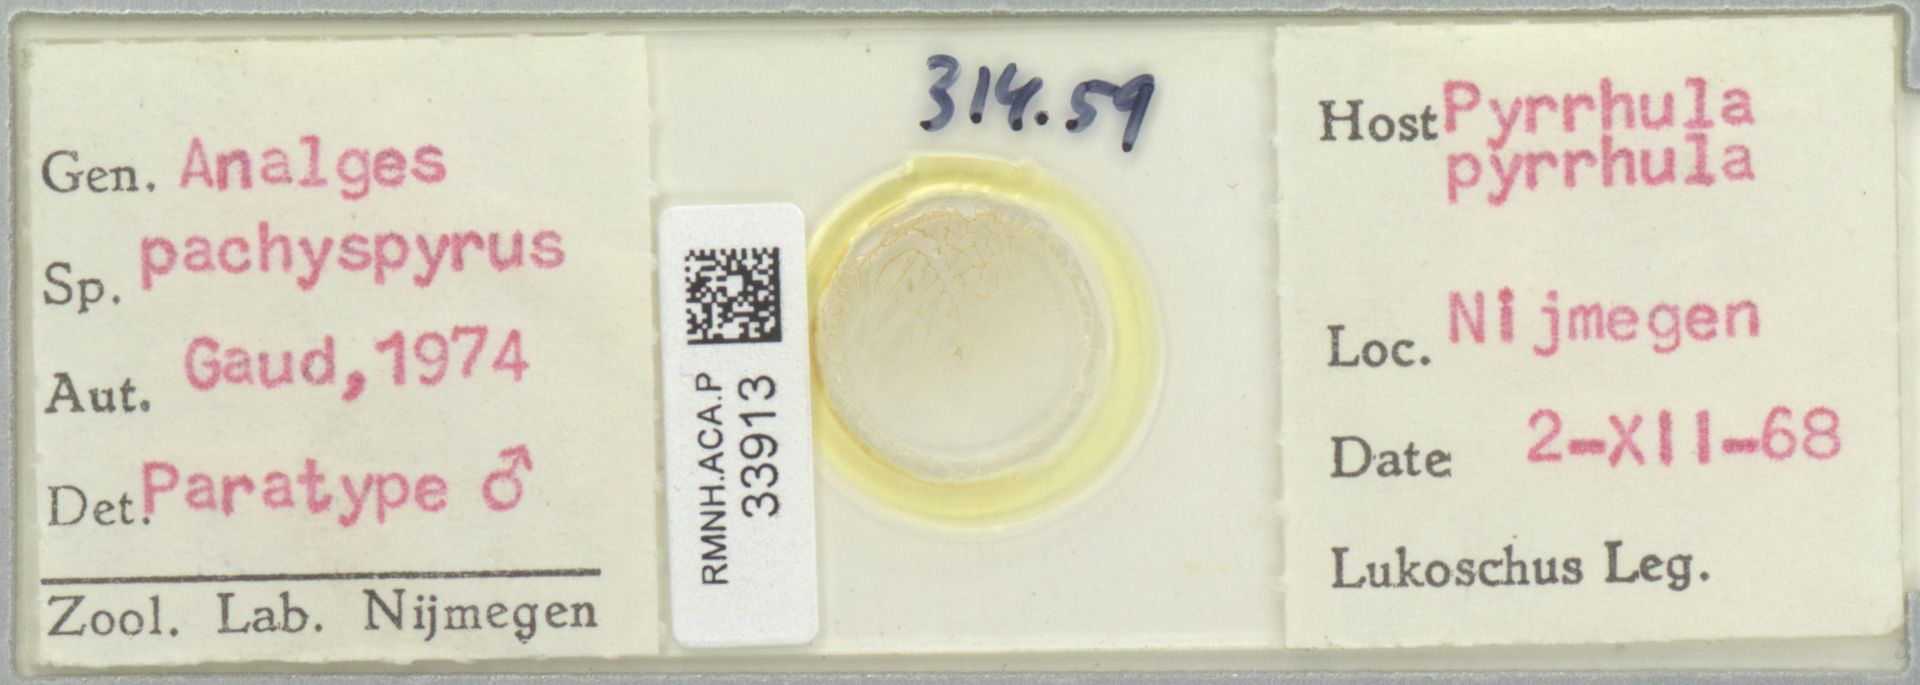

Espèces 1 à 16 sur 217
Acarus siro
Linnaeus, 1758
36 occurrences
36 medias

Caloglyphus geotruporum
Zachvatkin, 1941
2 occurrences
2 medias

Thyreophagus corticalis
A.D. Michael, 1885
12 occurrences
12 medias

Thyreophagus entomophagus
Laboulbène & Robin, 1862
7 occurrences
7 medias

Achipteria coleoptrata
Linnaeus, 1758
63 occurrences
63 medias

Achipteria nitens
Nicolet, 1855
7 occurrences
7 medias

Dichobrephosceles actitidis
Canestrini, 1878
2 occurrences
2 medias

Bimichaelia setigera
Berlese, 1904
1 occurrences
1 medias

Analges beaucournui
Gaud, 1973
3 occurrences
3 medias

Analges mucronatus
Buchholz, 1969
4 occurrences
4 medias

Analges pachysphyrus
Gaud, 1973
1 occurrences
1 medias
Analges sturninus
Gaud, 1973
1 occurrences
1 medias

Megninia cubitalis
Mégnin in Robin & Mégnin, 1877
15 occurrences
15 medias

Megninia ginglymura
Mégnin in Robin & Mégnin, 1877
94 occurrences
94 medias

Aphelacarus acarinus
Berlese, 1910
4 occurrences
4 medias

Avenzoaria calidridis
Oudemans, 1904
76 occurrences
76 medias
